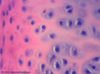
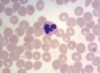
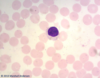

Histo Comprehensive Photomicrographs Flashcards
(66 cards)
1
Q

A
Stratified Non-keratinized Squamous Epithelium
2
Q

A
Stratified Non-Keratinized Squamous Epithelium
3
Q

A
simple columnar epithelium
4
Q

A
Transitional epithelium
5
Q

A
Simple (low) cuboidal epithelium
6
Q

A
simple columnar epithelium
7
Q

A
simple cuboidal
8
Q

A
sebaceous gland
9
Q

A
sublingual gland
10
Q

A
submandibular gland
11
Q

A
parotid gland
12
Q

A
submandibular gland
13
Q

A
areolar connective tissue
14
Q

A
white fibrous connective tissue (dense regular CT)
15
Q

A
adipose
16
Q
A
hyaline cartilage
17
Q

A
cancellous bone
18
Q

A
developing membrane bone
19
Q

A
Bone (dry ground)
20
Q

A
dry ground bone
21
Q
A
neutrophil
22
Q
A
lymphocyte
23
Q

A
(top) neutrophil
(bottom) monocyte
24
Q

A
skeletal muscle
25

skeletal muscle
26

smooth muscle
27

cardiac muscle
28

cornea
29

retina
30

cochlea XS
31
A?

Scala vestibuli
32
B?

Vestibular membrane
33
C?

cochlear duct
34
D?

stria vascularis
35
E?

organ of corti
36
F?

Basilar membrane
37
G?

scala tympani
38
A?

choroid
39
B?

pigmented epithelium
40
C?

Inner and outer segments of rods and cones
41
D?

outer nuclear layer
42
E?

outer plexiform layer
43
F?

Inner Nuclear Layer
44
G?

inner plexiform layer
45
H?

ganglion cell layer
46
I?

Axons of ganglion cells
47
J?

Internal limiting membrane
48
A?

stroma
49
B?

Bowman's Layer
50
C?

Corneal epithelium
51
D?

Corneal endothelium
52
E?

Descemet's membrane
53
A?

vestibular membrane
54
B?

Internal spiral tunnel of cochlear duct
55
C?

tectorial membrane
56
D?

inner hair cells
57
E?

inner tunnel
58
F?

cochlear duct with endolymph
59
G?

stria vascularis
60
H?

outer hair cells
61
I?

basilar membrane
62
J?

scala tympani with perilymph
63
A?

canaliculi
64
B?

lamellae
65
c?

haversian canal
66
D?

lacuna


